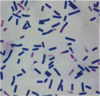

Pictures Flashcards
(19 cards)
What is shown here?

these creamy white plaques in the distal esophagus look like thrush a little & are suggestive of infectious esopaghitis.
What is shown here?

this is a methenamine silver stain of the mucosal tissue of the esophagus
pseudohyphae are seen.
suggestive of candida albicans infectious esophagitis
What is shown here?

peptic ulcer
possibly due to H. Pylori infection
pt will probably present with epigastric pain
A kid eats potato salad & has N/V a little diarrhea. What’s the diagnosis?

staph aureus food poisoning
rehydrate the kid!
What is this? Poor kid ate fried rice & had vomiting 3 hours later.

Bacillus cereus food poisoning
What is this? poor kid presented to ER w/ nausea & diarrhea after eating something funny.
Clostridium perfringens
gram + rods
What is this?

§Giardia lamblia (also called G. intestinalis) is a flagellated protozoan with a trophozoite (growing form) and a cyst (enviromental resistant form)
What is this?

giardia
What is this?

cryptosporidosis
C. parvum infection
What is this?

cryptosporidosis
C. parvum infection
What is this?

cryptosporidosis
C. parvum infection
on Kinyoun acid fast stain
What is this?

§Clostridium difficile is an anaerobic gram-positive, spore-forming rod
What is shown here?

pseudomembranous colitis (a type of inflammatory enterocolitis)
caused by C. diff
WHat is shown here?

pseudomembranous colitis on sigmoidoscopy
secondary to C diff infection
What is shown here?

shallow ulcers from C. diff toxins that depolymerize actin filaments & cause cells to detach & round up in the gut
C. diff inflammatory gastroenteritis
WHat is shown here?

campylobacter jejuni, bacterial dysentery
What does this show?

microscopy here reveals trophozoites w/ ingested RBCs
this can be used to diagnose E. histolytica amebiasis
WHat does this show?

flask-shaped ulcer
parasite releases cytotoxins that destroy leukocytes
characteristic of amebiasis
A 45-year-old migrant worker originally from Guatemala is evaluated for right upper quadrant pain, fever, and hepatic tenderness. He has had nausea and vomiting, but no diarrhea. Of note, he has been in the United States for approximately 10 months and was well until approximately 8 days ago. He reports a weight loss of 20 lbs. CBC reveals leukocytosis. He is found to have a large hepatic abscess on CT scan of the abdomen. Workup & diagnosis?

Amebiasis
Stool antigen test for Entamoeba histolytica was negative, but serum antibody was positive. The patient was treated with tinidazole and his symptoms began to resolve in less than a week.
If liver abscess were >12 cm, surgical aspiration may have been required